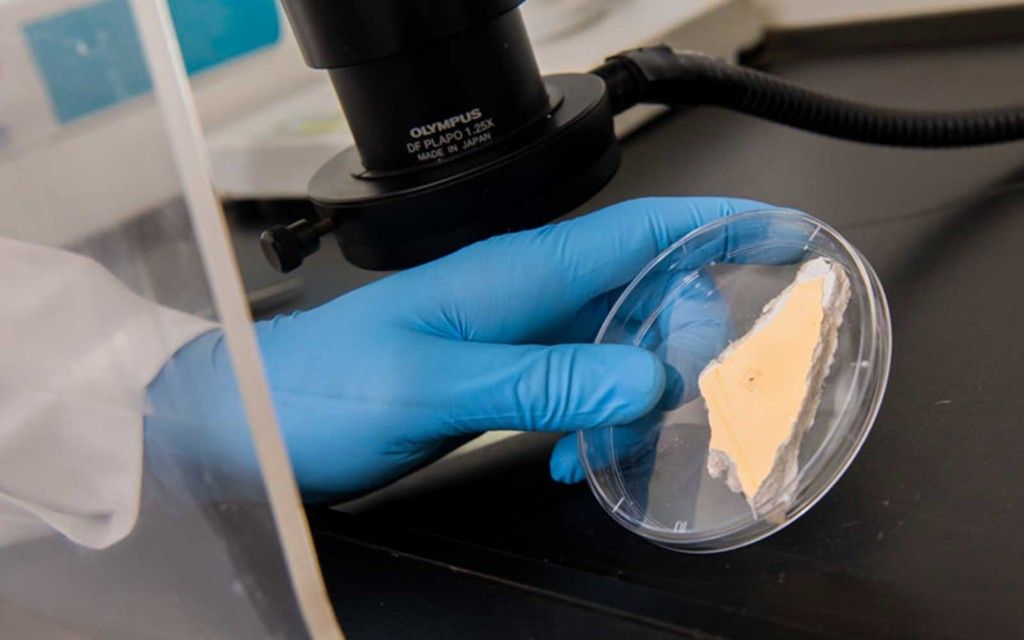
Lead in Paint Analysis

Metal Testers and Element Analyzers
Metal testers and element analyzers represent indispensable analytical tools across industries requiring rapid, accurate, non-destructive compositional analysis. From the comprehensive Metal Analyzer: ElvaX XRF Composition Testing capabilities to the precise XRF Metal Analyzer: Precise Alloy Composition performance, modern technology delivers exceptional analytical results. The XRF Metal Analyser: Metal Product Testing supports manufacturing excellence, while the Handheld Precious Metal Analyzer: Gold Silver Testing serves jewelry professionals with specialized capabilities.
The Handheld XRF: ElvaX ProSpector Metal Tester exemplifies portable industrial analysis, while dedicated XRF Gold Tester: ElvaX Jewelry Lab Karat Testing and XRF Gold Testing Machine: Precious Metal Verification instruments address precious metals authentication requirements. Professional applications benefit from the Handheld XRF Analyser: Professional Metal Analysis capabilities enabling field operations.
Understanding the XRF Detector: Metal Element Composition Scanner technology, selecting appropriate XRF Instrument: Material Chemistry Analysis Device configurations, and choosing optimal XRF Device: Professional Spectroscopy Equipment ensures analytical success across applications. Whether your requirements involve industrial quality control, precious metals authentication, scrap metal recycling, or manufacturing verification, metal testers and element analyzers deliver immediate value through improved efficiency, reduced costs, enhanced quality assurance, and comprehensive analytical capabilities supporting confident decision-making.
-
 Metal Testers and Element Analyzers: Comprehensive Guide to XRF Analysis TechnologyEinzelheiten
Metal Testers and Element Analyzers: Comprehensive Guide to XRF Analysis TechnologyEinzelheitenMetal testers and element analyzers have transformed material characterization across industries by providing instant, accurate compositional analysis without sample destruction. These sophisticated instruments utilize X-ray fluorescence technology to identify and quantify chemical elements in metals, alloys, precious materials, and diverse sample types within seconds. From manufacturing quality control and scrap metal recycling to precious metals authentication and regulatory compliance...
-
 Analyzers for Archaeological ScienceEinzelheiten
Analyzers for Archaeological ScienceEinzelheitenIn modern archaeology, X-ray fluorescence (XRF) analyzers have become essential tools for everyday research. Their simplicity, speed, and non-destructive nature greatly accelerate the determination of chemical composition, production technology, age indicators, usage patterns, and distribution paths of artifacts. Studying the physical and chemical properties of archaeological objects helps identify their origin (production centers), manufacturing techniques, trade routes, chronological...
-
 XRF Gold AnalysisEinzelheiten
XRF Gold AnalysisEinzelheitenGold analysis is essential today to verify that products match declared quality and purity. Quick, accurate testing is vital for specialists in science, research labs, enterprises, jewelry manufacturing, precious metals trading, pawnshops, and retail stores. XRF gold analyzers provide a reliable, non-destructive solution for these needs.
-
 Coating Thickness AnalysisEinzelheiten
Coating Thickness AnalysisEinzelheitenCoating analysis reveals the elemental composition of surface layers on materials, parts, or products without causing damage. For example, it can determine the makeup of a coating on an alloy component or check jewelry for gilding and unwanted impurities. This technique is widely applied across heavy and light industry, construction, utilities, and other sectors.
-
 Sulfur in Oil AnalysisEinzelheiten
Sulfur in Oil AnalysisEinzelheitenDetermining sulfur content in oil and petroleum products — including gasoline, diesel fuel, motor oils, and transmission fluids — ranks among the most essential tasks in the industry. A dependable sulfur analyzer plays a key role here, helping to confirm that sulfur levels stay within strict regulatory limits. Sulfur contributes to sulfite formation in vehicle exhaust, leading to environmental pollution. Authorities continue to lower the maximum allowed sulfur content in fuels each year....
-
Lead in Paint AnalysisEinzelheiten
Lead in Paint AnalysisEinzelheitenLead ranks among the most hazardous heavy metals, posing serious risks to human health by damaging the central nervous system and other vital functions. Exposure is particularly concerning for young children, whose developing brains are highly vulnerable, but it also threatens adults — especially those in construction, demolition, renovation, or older building maintenance roles. Inhalation of lead-containing dust or contact with contaminated surfaces can contribute to elevated blood...
-
 XRF Device: Professional Spectroscopy EquipmentEinzelheiten
XRF Device: Professional Spectroscopy EquipmentEinzelheitenProfessional spectroscopy demands precision, reliability, and versatility analyzing elemental composition across diverse materials supporting critical quality control, research, and compliance applications. XRF devices represent sophisticated professional spectroscopy equipment delivering comprehensive elemental analysis from sodium through uranium through advanced X-ray fluorescence technology. These specialized analytical instruments combine high-performance detection systems, optimized...
-
 XRF Instrument: Material Chemistry Analysis DeviceEinzelheiten
XRF Instrument: Material Chemistry Analysis DeviceEinzelheitenMaterial chemistry determines fundamental properties across industries—alloy strength, coating adhesion, catalyst activity, glass clarity, ceramic durability, polymer stability. XRF instruments revolutionize material chemistry analysis by delivering comprehensive elemental composition from sodium through uranium in minutes without destroying samples. These sophisticated X-ray fluorescence devices analyze metals, minerals, ceramics, polymers, liquids, powders, and solid materials revealing...
-
 XRF Detector: Metal Element Composition ScannerEinzelheiten
XRF Detector: Metal Element Composition ScannerEinzelheitenThe detector represents the critical technological heart of every XRF metal composition scanner—capturing fluorescent X-rays emitted from tested materials and converting them into precise elemental data within seconds. This sophisticated sensor technology determines analytical performance, measurement speed, detection sensitivity, and overall capabilities of X-ray fluorescence systems. From silicon PIN detectors offering cost-effective performance to advanced silicon drift detectors...
-
 Handheld XRF Analyser: Professional Metal AnalysisEinzelheiten
Handheld XRF Analyser: Professional Metal AnalysisEinzelheitenProfessional metal analysis demands precision, speed, and flexibility in environments where material verification drives quality, safety, and profitability. Handheld XRF analysers deliver laboratory-quality elemental analysis through portable instruments weighing just 1-2 kilograms, providing instant compositional data wherever metals exist—manufacturing floors, construction sites, scrap yards, mining operations, or field installations. This advanced X-ray fluorescence technology identifies...
